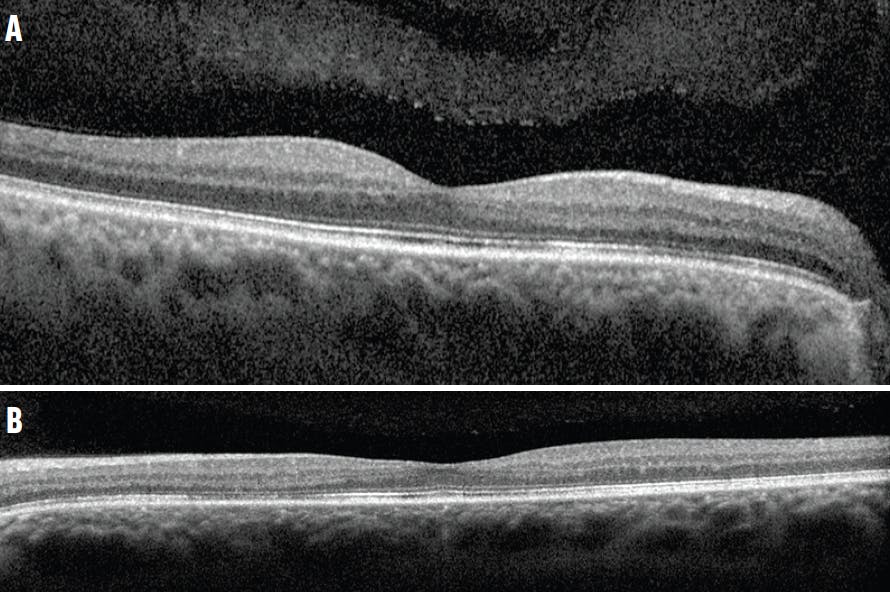
<p>Figure 2. OCT showed disruption of the inner segment/outer segment junction (ie, ellipsoid zone) in the right (A) and left (B) eyes.</p>

Acute macular neuroretinopathy (AMN) is a rare retinal disease, the etiology of which is not entirely understood. It is most commonly diagnosed in young, otherwise healthy women.1 Risk factors associated with AMN may include use of contraceptives, caffeine or cocaine intake, trauma, viral illness, and vaccination.2
Studies report different ophthalmological manifestations of COVID-19, conjunctivitis being the most common.3-6 We present a case of COVID-19-associated bilateral AMN in a previously healthy man. Clinical manifestation typically involves sudden onset of single or multiple unilateral or bilateral paracentral scotomas with unaffected visual acuity.
THE CASE
A 43-year-old man presented with an acute onset of visual field defects in each eye, located in the upper outer quadrant in the right and more centrally in the left eye. He tested positive for COVID-19 infection via a PCR test and experienced mild respiratory symptoms and fever, for which no specific medication was required. The visual field defects started 3 days after the beginning of COVID-19 infection, following a high fever. His medical history was otherwise unremarkable. He reported no prior eye injury, medication usage, or sungazing.
His BCVA was unremarkable in his right eye (6/60 OD), but significantly decreased in his left eye (6/95 OS). His IOP and anterior segment findings were unremarkable. The fundoscopic examination revealed reddish-brown petaloid perifoveal lesions, with the tips pointing toward the center of the fovea (Figure 1). Findings on the optic nerve head were unremarkable. OCT imaging showed subtle disruption of the ellipsoid zone (Figure 2), while OCT angiography (OCTA) showed inner choroidal flow void that corresponded to the abnormal regions on OCT (Figure 3).

Figure 1. Fundoscopic examination revealed reddish-brown petaloid perifoveal lesions in the right (A) and left (B) eyes.
Figure 2. OCT showed disruption of the inner segment/outer segment junction (ie, ellipsoid zone) in the right (A) and left (B) eyes.
Visual field testing revealed a perifoveal scotoma in the right eye and a central foveal scotoma in the left eye, which were causing his reduced visual acuity (Figure 4). Multifocal electroretinography was also performed, showing reduced amplitudes corresponding to the retinal lesions (Figure 5).

Figure 4. Visual field testing showed a perifoveal scotoma on the right eye (A) and a central foveal scotoma in the left eye (B).

Figure 5. Multifocal electroretinography showed reduced amplitudes in the right (A) and left (B) eyes.
The patient’s subjective complaints and the diagnostic testing suggested bilateral AMN associated with COVID-19. Because this disease is considered to be self-limiting, no treatment was required. The patient reported subjective improvement 5 months following the initial examination with BCVA of 6/60 OD and 6/48 OS, along with improvements on OCTA (Figure 6). He still reported the presence of a visual field scotoma in each eye, however.
ETIOLOGY AND MANAGEMENT
Although the etiology of AMN is unclear, it is proposed that deep retinal vascular ischemia found in AMN can result from COVID-19 infection because the angiotensin-converting enzyme 2 (ACE-2) is the main receptor for coronavirus, causing multi-organ complications.2 ACE-2 is present in the retina, making it a target for COVID-19 and a possible cause of deep vascular ischemia in AMN.
Different mechanisms can cause retinal hypoperfusion and ischemia, including vasoconstriction due to an increase in catecholamine release; lack of choriocapillaris autoregulation and decreased flow; hyperviscosity; endothelial dysfunction; coagulopathy; immune complex deposition; or acquired hypercoagulable state, each of which many occur in the inflammatory phase of COVID-19.1 Cytokine storm and overactivation of immunological response, typical events during COVID-19 infection, may also cause systemic vascular injuries, including to the retina.7
One case report used treatment with systemic corticosteroids, which led to the improvement of scotomas.8 Other cases report gradual resolution of the lesions over a few months, often with persistent visual field scotomas. Although this case showed improvement in OCTA findings, another reported persistence of choroidal flow void with improvement in retinal hyperreflectance on OCT.9
One ophthalmological disease with an ischemic event similar to that seen in AMN is paracentral acute middle maculopathy, which also presents with paracentral macular lesions, hyperintense OCT lesions, and subjective paracentral scotomas.1 Fluorescein angiography can be used to differentiate these conditions, since it is unremarkable in AMN.
BEWARE OF OCULAR COMPLICATIONS WITH COVID-19
This case raises awareness of possible retinal vascular injuries and ischemia caused by COVID-19 acute infections, although further research is needed to completely understand the etiology of this disease.
1. Bhavinsar KV, Lin S, Rahimy E, et al. Acute macular neuroretinopathy: a comprehensive review of the literature. Surv Ophthalmol. 2016;61(5):538‐565.
2. Masjedi M, Pourazizi M, Hosseini NS. Acute macular neuroretinopathy as a manifestation of coronavirus disease 2019: A case report. Clin Case Rep. 2021;9(10):04976.
3. An eye on COVID-19: a meta-analysis of positive conjunctival reverse transcriptase-polymerase chain reaction and SARS-CoV-2 conjunctivitis prevalence. Optom Vis Sci. 2021;98(5):429-436.
4. Xia J, Tong J, Liu M, Shen Y. Evaluation of coronavirus in tears and conjunctival secretions of patients with SARS-CoV-2 infection. J Med Virol. 2020;92(6):589-594.
5. Situala RK, Khatri A, Janani MK, et al. Unfolding COVID-19: lessons-in-learning in ophthalmology. Clin Ophthalmol. 2020;14:2807-2820.
6. Hu K, Patel J, Swiston C, Patel BC. Ophthalmic manifestations of coronavirus (COVID-19). StatPearls [Internet]. National Library of Medicine. May 24, 2022. Accessed May 2, 2023. www.ncbi.nlm.nih.gov/books/NBK556093
7. Gascon P, Briantais A, Bertrand E, et al. COVID-19-associated retinopathy: a case report article history. Ocul Immunol Inflamm. 2020;28(8):1293-1297.
8. Hashimoto Y, Saito W, Mori S, Saito M, Ishida S. Increased macular choroidal blood flow velocity during systemic corticosteroid therapy in a patient with acute macular neuroretinopathy. Clin Ophthalmol. 2012;6:1645-1649.
9. Lee SY, Cheng JL, Gehrs KM, et al. Choroidal features of acute macular neuroretinopathy via optical coherence tomography angiography and correlation with serial multimodal imaging. JAMA Ophthalmol. 2017;135(11):1177-1183.
















_1773249222.png?auto=compress,format&w=75)










